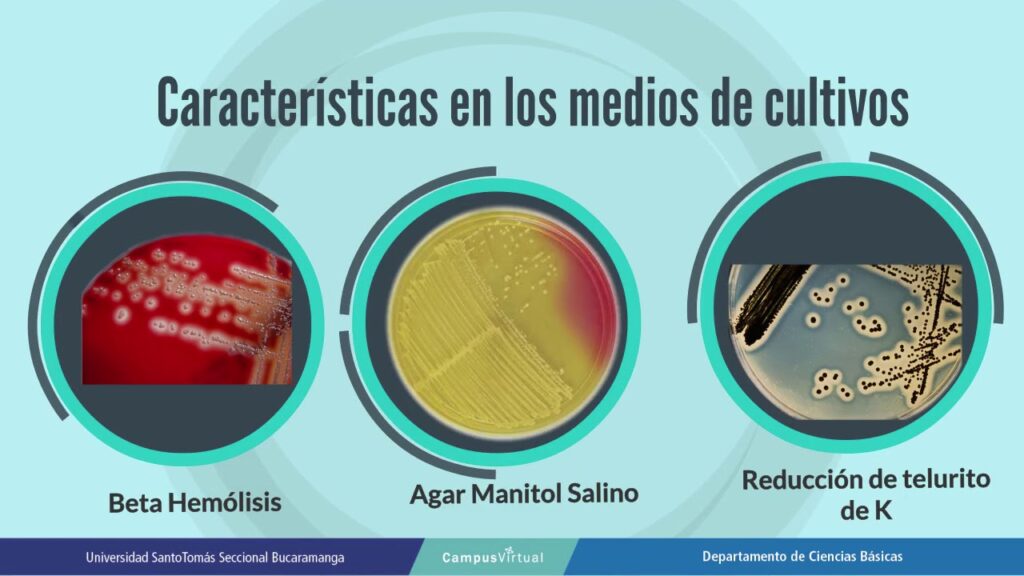
Cómo detectar toxina de Staphylococcus aureus en alimentos

Para garantizar la seguridad de las personas y mascotas después de fumigar, es importante seguir las recomendaciones del profesional encargado del tratamiento. Generalmente, se aconseja estar fuera de casa entre 4 y 8 horas después de la fumigación, pero este tiempo puede variar dependiendo del tipo de plaguicida utilizado y la gravedad de la infestación. Es fundamental leer detenidamente las instrucciones del producto y seguir las indicaciones del personal especializado para minimizar los riesgos para la salud.
Además, es aconsejable ventilar adecuadamente la vivienda antes de regresar, abriendo puertas y ventanas para permitir que el aire circule y los residuos de los productos se disipen. Es importante también limpiar y desinfectar superficies de contacto como mesas, encimeras y utensilios de cocina para eliminar cualquier rastro de sustancias químicas.
En caso de tener dudas sobre el tiempo de espera después de la fumigación, lo más recomendable es contactar con la empresa de control de plagas o el profesional responsable del tratamiento para obtener orientación personalizada. La seguridad de las personas y el bienestar de las mascotas deben ser la prioridad en estos casos, por lo que es fundamental seguir las indicaciones al pie de la letra para evitar cualquier riesgo para la salud.
Entendiendo el proceso de fumigación y sus efectos
Entendiendo el proceso de fumigación y sus efectos:
La fumigación es un procedimiento comúnmente utilizado para eliminar plagas no deseadas en hogares, oficinas, y otros espacios. Sin embargo, es importante comprender en profundidad este proceso y sus posibles efectos para garantizar la seguridad de las personas que habitan en el lugar fumigado.
Algunos de los productos químicos utilizados en la fumigación pueden ser nocivos para la salud humana si se inhalan en altas concentraciones o si se tiene contacto directo con ellos. Por esta razón, es fundamental seguir las recomendaciones de los profesionales fumigadores y tomar las medidas necesarias para protegerse adecuadamente durante y después del proceso de fumigación.
Efectos de la fumigación en la salud:
Los efectos de la fumigación en la salud pueden variar dependiendo del tipo de pesticida utilizado, la cantidad aplicada, y la ventilación del espacio fumigado. Algunos de los posibles efectos adversos para la salud incluyen:
- Irritación en ojos, nariz y garganta.
- Dolor de cabeza y mareos.
- Náuseas y vómitos.
- Problemas respiratorios.
Es importante tener en cuenta que estos efectos suelen ser temporales y suelen desaparecer una vez que el lugar fumigado se ventila adecuadamente.
Duración recomendada de ausencia después de la fumigación:
Para garantizar la seguridad de las personas que habitan en un espacio fumigado, es esencial respetar el tiempo de espera recomendado antes de volver a habitarlo. La duración de la ausencia dependerá del tipo de pesticida utilizado, las condiciones de ventilación del lugar y las indicaciones específicas del profesional fumigador.
En general, se recomienda permanecer fuera del lugar fumigado durante al menos 4 a 6 horas, aunque este tiempo puede variar. Es fundamental seguir las instrucciones proporcionadas por el equipo de fumigación para asegurar que el espacio esté seguro para su ocupación nuevamente.
Recuerda que la ventilación adecuada del lugar fumigado es clave para acelerar el proceso de dispersión de los productos químicos y reducir al mínimo los riesgos para la salud.
Factores que influyen en el tiempo de espera tras la fumigación
Es fundamental tener en cuenta diversos factores que pueden influir en el tiempo de espera necesario después de realizar una fumigación en el hogar. Estos elementos determinarán cuándo es seguro regresar a casa sin correr riesgos para la salud.
1. Tipo de producto utilizado:
Dependiendo del tipo de producto que se haya utilizado en la fumigación, el tiempo de espera puede variar considerablemente. Algunos productos químicos requieren un período de ventilación más extenso que otros, por lo que es crucial seguir las recomendaciones del fabricante.
2. Tamaño y ventilación del espacio:
El tamaño del espacio fumigado y el nivel de ventilación del mismo son factores determinantes. En espacios más grandes o con una ventilación deficiente, el tiempo de espera suele ser mayor para permitir que los químicos se dispersen por completo y el ambiente sea seguro para la ocupación.
3. Sensibilidad de los ocupantes:
La sensibilidad de las personas que habitan la vivienda también es un aspecto importante a considerar. Algunas personas pueden ser más susceptibles a las sustancias químicas utilizadas en la fumigación, por lo que se recomienda ser prudente y extender el tiempo de espera si es necesario para evitar posibles reacciones alérgicas o problemas de salud.
El tiempo de espera después de una fumigación puede variar dependiendo del producto utilizado, el tamaño y ventilación del espacio fumigado, y la sensibilidad de los ocupantes. Es fundamental seguir las indicaciones del profesional encargado de la fumigación y no regresar al hogar hasta que sea seguro hacerlo para garantizar la salud y el bienestar de todos los habitantes.
Recomendaciones de seguridad para regresar a casa después de la fumigación

Las recomendaciones de seguridad son fundamentales al momento de regresar a casa después de la fumigación para garantizar la salud de todos los habitantes del hogar. Es crucial seguir ciertas pautas para minimizar los riesgos asociados con los productos químicos utilizados durante el proceso de fumigación.
Algunas recomendaciones importantes a tener en cuenta incluyen:
- Ventilación adecuada: Es esencial asegurarse de que la casa esté bien ventilada antes de regresar. Abrir puertas y ventanas para permitir que el aire fresco circule y elimine cualquier residuo de los productos químicos utilizados en la fumigación.
- Esperar el tiempo recomendado: Después de la fumigación, es importante seguir las indicaciones del equipo de fumigación en cuanto al tiempo que debe transcurrir antes de regresar a casa. Este período puede variar dependiendo de los productos utilizados, por lo que es crucial seguir estas instrucciones al pie de la letra.
- Limpieza adecuada: Antes de regresar, es aconsejable limpiar las superficies donde se aplicaron los productos químicos. Utilizar agua y jabón para eliminar cualquier residuo y asegurarse de que los objetos expuestos estén limpios.
Es importante recordar que la seguridad y el bienestar de la familia son la prioridad al regresar a casa después de la fumigación. Seguir estas recomendaciones ayudará a garantizar un entorno saludable y libre de riesgos para todos los habitantes.
Procedimientos de limpieza y precauciones adicionales post-fumigación
Una vez que se ha llevado a cabo la fumigación en un espacio, es fundamental seguir ciertos procedimientos de limpieza y tomar precauciones adicionales para garantizar la seguridad de las personas que habitan en ese lugar. Estas medidas contribuyen a minimizar los riesgos de exposición a los químicos utilizados durante el proceso de fumigación.
Algunas de las acciones que se deben realizar como parte de los procedimientos de limpieza post-fumigación incluyen:
- Eliminar los alimentos y utensilios expuestos: Es importante retirar cualquier alimento que haya quedado expuesto durante la fumigación, así como los utensilios de cocina que puedan haber estado en contacto con los químicos utilizados.
- Lavar la vajilla y utensilios: Si por alguna razón no fue posible retirar los utensilios de cocina antes de la fumigación, es crucial lavarlos a fondo con agua y detergente antes de volver a utilizarlos.
- Limpiar superficies: Es recomendable limpiar todas las superficies, como mesas, encimeras y pisos, con agua y jabón para eliminar cualquier residuo de los productos químicos fumigantes.
En cuanto a las precauciones adicionales que se deben tener en cuenta después de la fumigación, se destacan las siguientes:
- Ventilación adecuada: Es fundamental ventilar el espacio fumigado durante un período de tiempo suficiente para permitir que los residuos de los químicos se dispersen y el ambiente se renueve completamente.
- Evitar el contacto directo: Se recomienda evitar el contacto directo con las superficies fumigadas, especialmente si no se ha realizado la limpieza post-fumigación.
- Lavado de ropa y textiles: En caso de que la ropa o textiles hayan estado expuestos durante la fumigación, es importante lavarlos antes de volver a utilizarlos para eliminar cualquier residuo químico.
Seguir rigurosamente estos procedimientos de limpieza y precauciones adicionales no solo contribuye a mantener un ambiente seguro y saludable después de la fumigación, sino que también ayuda a proteger la salud de las personas y mascotas que habitan en el lugar fumigado.
Preguntas frecuentes
¿Cuánto tiempo hay que estar fuera de casa después de fumigar?
Depende del tipo de fumigación realizada, pero por lo general se recomienda permanecer fuera de casa entre 4 a 8 horas.
¿Es seguro para las mascotas estar en casa después de fumigar?
Es recomendable seguir las indicaciones del profesional fumigador, pero por lo general se aconseja mantener a las mascotas fuera de casa durante al menos 4 horas.
¿Es necesario limpiar la casa después de la fumigación?
Sí, se recomienda limpiar las superficies donde se preparan alimentos y los utensilios que estuvieron expuestos durante la fumigación, siguiendo las indicaciones del fumigador.
¿Cuánto tiempo dura el efecto de la fumigación?
El tiempo de efectividad de la fumigación puede variar dependiendo del tipo de plagas tratadas, pero generalmente puede durar de varias semanas a varios meses.
¿Puedo realizar una fumigación por mi cuenta?
Se recomienda contratar a profesionales capacitados para realizar fumigaciones, ya que el mal uso de productos químicos puede ser peligroso para la salud.
¿Qué debo hacer si tengo dudas sobre la fumigación?
Si tienes dudas o inquietudes sobre el proceso de fumigación, es importante consultar con la empresa fumigadora para aclarar cualquier pregunta.
| Puntos clave sobre la fumigación en casa |
|---|
| 1. Tiempo recomendado para permanecer fuera de casa después de fumigar. |
| 2. Precauciones a tomar con mascotas durante la fumigación. |
| 3. Importancia de limpiar áreas expuestas durante la fumigación. |
| 4. Duración del efecto de la fumigación en el control de plagas. |
| 5. Riesgos de realizar fumigaciones caseras sin conocimientos previos. |
¡Déjanos tus comentarios y visita nuestros otros artículos sobre control de plagas para más información útil!